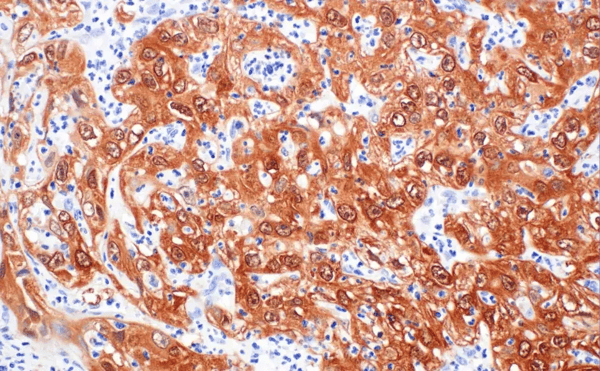
DAT-LEFT-88667_fig08_IHC-P_1989_20250630142005

p16INK4A has become a widely used marker for identifying senescent cells in tissue, yet interpreting expression patterns in IHC data can be surprisingly difficult. Across studies, staining intensity and distribution often vary with tissue type, senescence trigger, and technical approach.
In this post, we take a closer look at p16 biology in the context of senescence and cell cycle regulation, discuss factors that contribute to variable IHC readouts, and highlight practical considerations for choosing and using antibodies in senescence studies.
|
|
Browse the p16INK4A antibody products discussed in the blog:
|
|
What role does p16 play in cellular senescence and aging?
Cell cycle regulation is vital to maintain tissue homeostasis and prevent sustained proliferative signaling and resistance to cell death, two of the Hallmarks of Cancer first described by Doctors Robert Weinberg and Douglas Hanahan. During development, the cell cycle is regulated by three of the four INK4 family members, and their expression subsequently declines with age. In contrast, founding member p16INK4A presents low expression in the early stages of development and steadily increases as we age.1
Cellular senescence is a stress response mechanism that prevents cells with extensive DNA damage and harmful genetic mutations from dividing. Thus, cellular senescence is important in preventing cancer and is typically triggered by intrinsic and extrinsic stressors, including telomere shortening, DNA damage, and oxidative stress.
Paradoxically, the accumulation of senescent cells as we age has also been linked to age-related pathologies, including cancer.2
Like other INK4 family members, p16 is a cell cycle regulator that plays a role in the G1 to S phase transition of the cell cycle. Acting through the retinoblastoma (Rb) pathway, p16INK4A binds to cyclin-dependent kinase 4 and 6 (CDK4 and CDK6) to irreversibly inhibit its activity, prevent transition to S phase, and subsequently cease cellular proliferation. Frequently, p16 is selectively targeted for early inactivation in several cancers, either through point mutations or complete loss, suggesting that its expression is essential for preventing cancer—especially as we age.1,3
This association has been demonstrated in mouse studies, where p16INK4A expression was shown to increase sharply later in life. Whereas the three other members of the INK4 family—p15INK4B, p18INK4C, and p19INK4D—were widely expressed during early development, p16 is suppressed in healthy, young tissue, and expression increases over time.1
The ability of p16 to cease proliferation has been observed as an important role in tumor suppression, and both mutations in and the loss of the gene in its entirety have been linked to several types of cancers. In most cancers, p16 is typically inactivated early on to enable disease progression.2 However, the normal role of p16 remains unclear, and the expression levels are highly variable in several cancer types.3
Related Pathway Diagrams
 |
Senescence Signaling Pathway Visualize upstream stress sensors, CDK inhibitors, and downstream effectors that help establish and maintain the SASP phenotype in aging and cancer. |
 |
G1/S Checkpoint Visualize how cyclins, CDK4/6, Rb, and CDK inhibitors such as p16INK4A control G1–S transition. |
How does p16INK4A contribute to cancer progression?
Senescent cells can exhibit dramatic changes in their secretome—a process known as the senescence-associated secretory phenotype (SASP)—that include an upregulation and release of several pro-inflammatory cytokines, proteases, and growth factors that can affect the surrounding tissues. As a consequence, this accumulation of senescent cells during aging without their proper removal by the immune system may contribute to the progression of tumor development.
Observations of highly expressed p16 correlate with some types of pRb-negative and malignant cancers, including cervical carcinoma (Figure 1), urothelial carcinoma, glioblastoma multiforme, head and neck squamous cell carcinoma, lung squamous cell carcinoma, prostate adenocarcinoma, and cutaneous melanoma.2,3
Figure 1. Immunohistochemical (IHC) analysis of paraffin-embedded human glassy cell carcinoma of the cervix using p16 INK4A (F9T1L) Rabbit Monoclonal Antibody #88667.
Figure 1. Immunohistochemical (IHC) analysis of paraffin-embedded human glassy cell carcinoma of the cervix using p16 INK4A (F9T1L) Rabbit Monoclonal Antibody #88667.
However, the significance of p16 overexpression remains unclear. Further research is needed to determine whether it is just a futile attempt to prevent cellular proliferation due to a dysfunctional G1-S phase checkpoint, or if this overexpression is eliciting a strong immune-oncogenic response.
An extensive study on p16 expression in 124 different tumor types found a link between HPV infection and strong expression of p16 in certain cancers, including cervical, uterine, and penile.3,5 Even so, this link is inconsistent, and additional research is needed to understand the multiple roles that p16 exhibits during tumor progression.
Since the variation observed in senescence biomarker expression can depend on senescence stimuli, cell type, and timing, it is important to use multiple senescence-associated markers, like p16, for proper identification and characterization.
Why IHC-validated Antibodies Matter for Senescence Research
Immunohistochemistry (IHC) is frequently used by cancer researchers to detect specific biomarkers in a tissue sample for the diagnosis and characterization of cancer. Over 3,000 studies have used IHC to study p16 biomarker expression in normal and tumor tissues. Yet, the role of p16 expression in many cancers remains unclear due to the highly variable results. This variability is likely due to:
-
Non-validated or poorly characterized antibodies
-
Use of different immunostaining and antigen retrieval protocols
-
Non-standardized criteria used to determine p16 expression levels across labs3
Unfortunately, this challenge is not unique to p16. Across the broader research landscape, inadequately validated antibodies are a major driver of irreproducible data. A large-scale, independent analysis by the Antibody Characterization through Open Science (YCharOS) initiative found that roughly 50% of commercially available antibodies fail to demonstrate consistent specificity across applications.4 For markers like p16 that already show tissue- and context-dependent expression, this makes it especially difficult to connect senescence phenotypes with relevant clinical or functional endpoints.
Choosing rigorously validated antibodies from manufacturers that provide transparent, application-specific validation data (including KO, orthogonal strategies, and clear tissue context) can help ensure antibody reliability. For example, the CST validation data below shows that clones F9T1L and F2T7H produce robust staining in paraffin‑embedded human ovarian serous papillary carcinoma (Figure 2) and a 4T1 syngeneic tumor (Figure 3), two disease‑relevant models commonly used to study p16‑linked senescence and tumor biology. These IHC data represent one component of a broader CST validation campaign designed to confirm that these clones reliably recognize endogenous levels of p16.
 |
 |
| Figure 2. IHC analysis of paraffin-embedded human ovarian serous papillary carcinoma using p16 INK4A (F9T1L) Rabbit Monoclonal Antibody #88667. | Figure 3. IHC analysis of paraffin-embedded 4T1 syngeneic tumor using p16 INK4A (F2T7H) Rabbit Monoclonal Antibody #23200. |
When validating an antibody, CST scientists follow a rigorous, application-specific workflow to establish target specificity and performance for each tested application. For validation in immunohistochemistry, steps include positive and negative paraffin-embedded cell pellets (Figure 5), multiple diseased and normal human and mouse tissues, as well as other methods.
 |
%20CANCER/23-CAN-00800/DAT-23200_fig09_IHC-P_1989_20250307105442_cropped2.webp?width=374&height=120&name=DAT-23200_fig09_IHC-P_1989_20250307105442_cropped2.webp) |
| Figure 4. IHC analysis of paraffin-embedded Renca syngeneic tumor using p16 INK4A (F2T7H) Rabbit Monoclonal Antibody #23200 (left) compared to concentration-matched Rabbit (DA1E) Monoclonal Antibody IgG Isotype Control #3900 (right). | Figure 5. IHC analysis of paraffin-embedded Renca cell pellet (left, positive) or NIH/3T3 cell pellet (right, negative) using p16 INK4A (F2T7H) Rabbit Monoclonal Antibody #23200. |
“When we validate antibodies for IHC, no single image or data point is enough to establish specificity," explains Katherine (Katie) Crosby, Senior Director of Antibody Applications & Validation at CST. "Binary models are valuable, but they’re only one part of a broader validation strategy that spans multiple positive and negative tissues, isotype controls, cell pellets, and other assays. It’s that full body of evidence—like the validation data shown here for our p16INK4A antibodies, which represents just a subset of the testing we conducted—that tells you that the IHC signal is truly antigen‑specific. This is what allows us to confidently stand behind our antibodies’ performance.”
When you start with IHC-ready reagents, you gain confidence that the differences in p16 staining patterns are driven by true biology rather than reagent performance, allowing you to focus on experimental design and data interpretation instead of in-house validation.
p16INK4A: A Vital Biomarker for Studying Senescence in Aging & Cancer Research
Due to p16’s expression during cellular senescence, association with aging, and role as a cell cycle regulator, it is a key target for cancer research. To date, there have been a large number of p16INK4A research studies and an observed link between its expression and specific types of malignant cancers, yet the significance and role of p16 expression remains uncertain due to the highly variable results among the studies.
Ongoing research requires the use of IHC-validated antibodies for accurate detection and analysis of its expression to understand the pivotal roles it plays in cellular senescence, aging, and cancer research.
Because no single biomarker can capture all senescent cell states, designing a senescence-focused IHC panel involves decisions about which pathways to cover, which markers to combine, and how to interpret complex staining patterns. Download the Cellular Senescence guide to explore commonly used markers and practical examples of how to use p16 along with other markers to identify states of cell cycle arrest, DNA damage, and SASP activity.
References
-
Zindy F, Quelle DE, Roussel MF, Sherr CJ. Expression of the p16INK4A tumor suppressor versus other INK4 family members during mouse development and aging. Oncogene. 1997;15:203-211. doi: 10.1038/sj.onc.1201178
-
LaPak KM, Burd CE. The Molecular Balancing Act of p16INK4A in Cancer and Aging. Mol Cancer Res. 2013;12(2):167-83. doi: 10.1158/1541-7786.MCR-13-0350
-
De Wispelaere N, Rico SD, Bauer M, et al. High Prevalence of p16 Staining in Malignant Tumors. PLoS ONE. 2022;17(7):e0262877. doi: 10.1371/journal.pone.0262877
- Ayoubi R, Ryan J, Biddle MS, et al. Scaling of an antibody validation procedure enables quantification of antibody performance in major research applications. Elife. 2023;12:RP91645. Published 2023 Nov 23. doi:10.7554/eLife.91645
-
Liu Y, Sharpless NE. Tumor Suppressor Mechanisms in Immune Ageing. Curr Opin Immunol. 2009;21(4):431-439. doi: 10.1016/j.coi.2009.05.011
-
Nicolás I, Saco A, Barnadas E, et al. Prognostic Implications of Genotyping and p16 Immunostaining in HPV-positive Tumors of the Uterine Cervix. Mod Pathol. 2020;33:128-137. doi: 10.1038/s41379-019-0360-3
CST Content Marketing Manager Alexandra Foley contributed to writing this blog.23-CAN-00800








